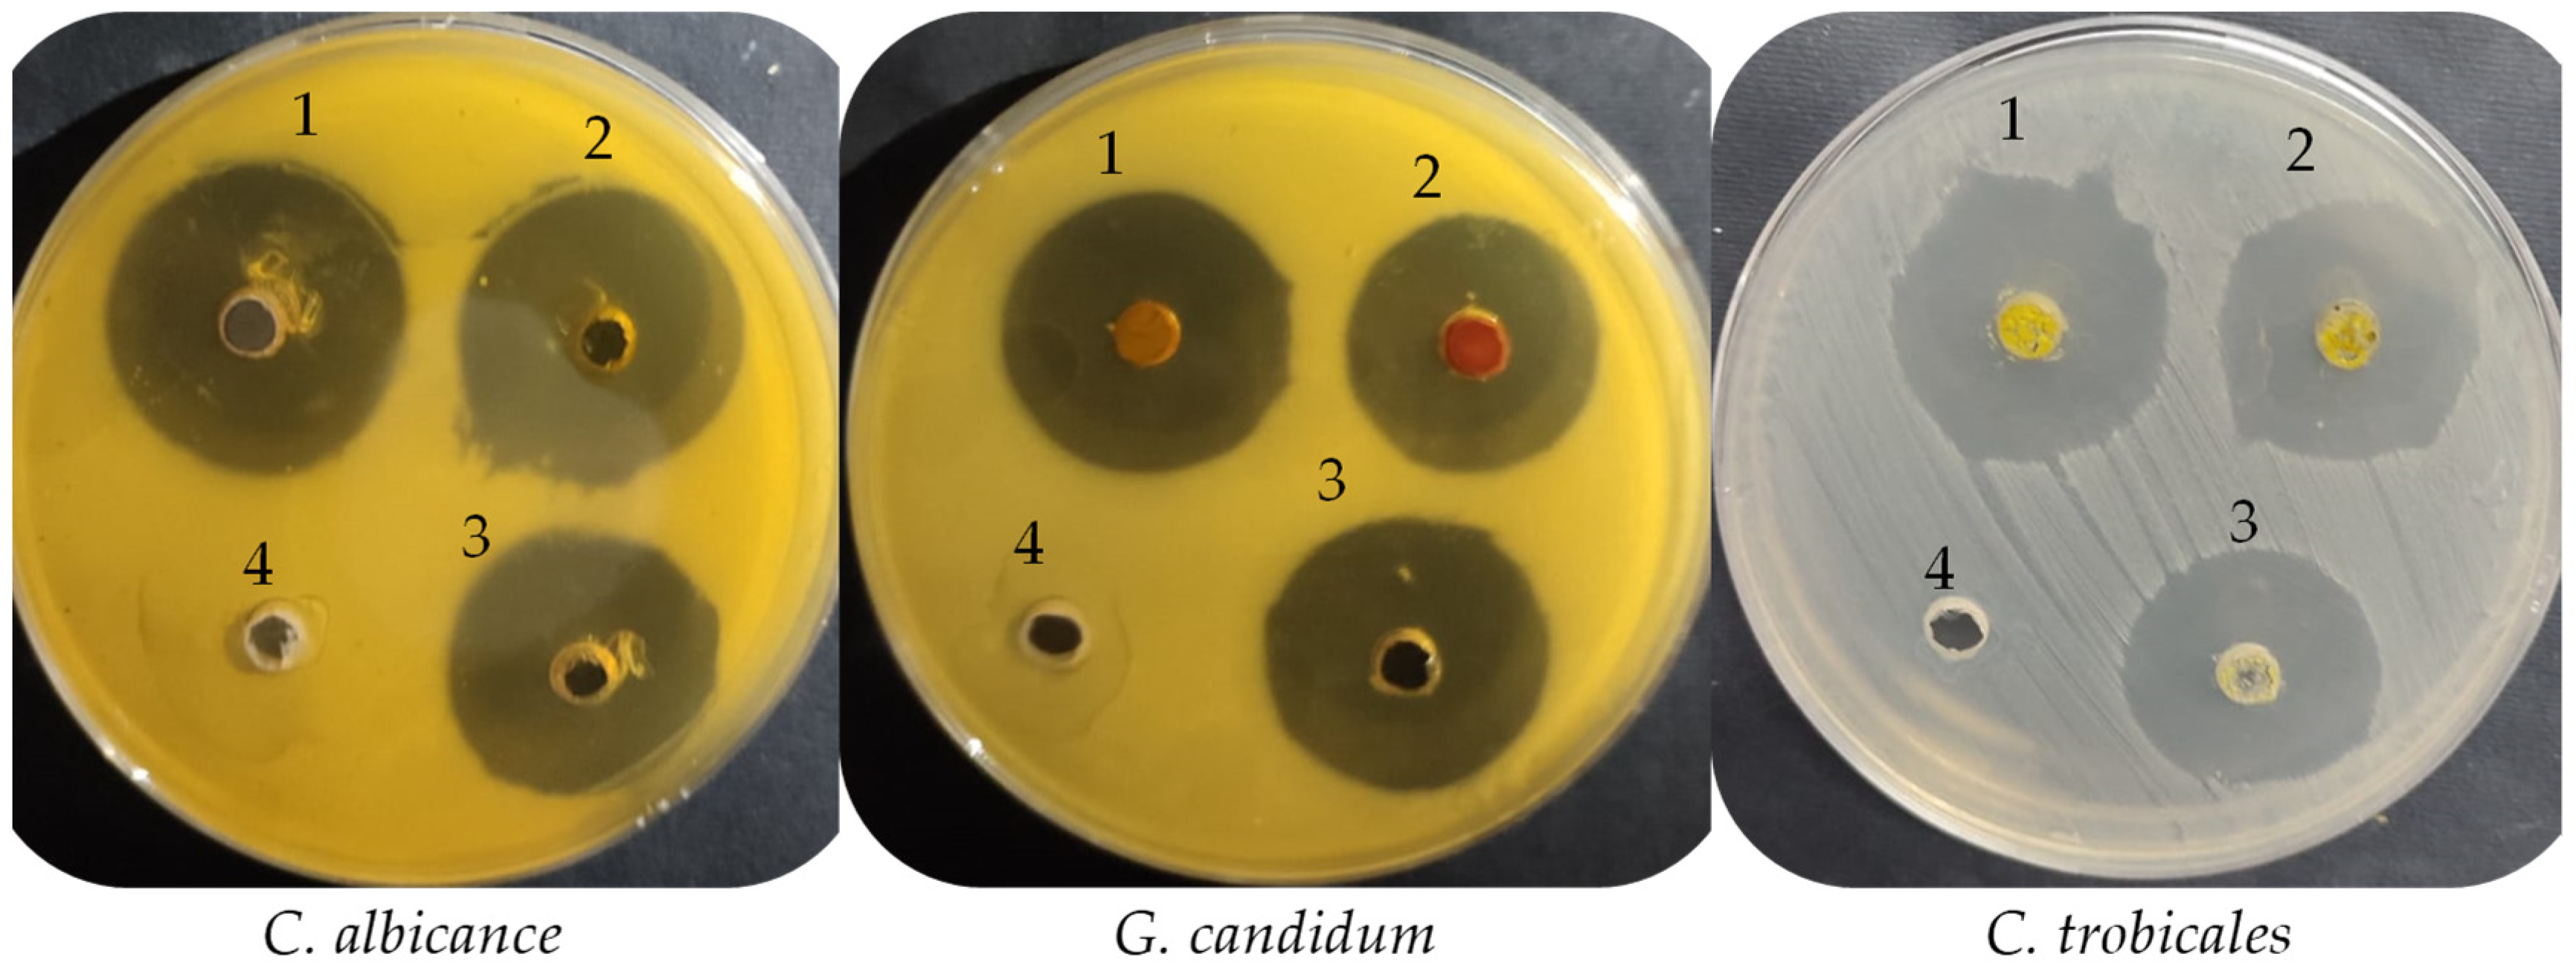

Anti-Yeasts, Antioxidant and Healing Properties of Henna Pre-Treated by Moist Heat and Molecular Docking of Its Major Constituents, Chlorogenic and Ellagic Acids, with Candida albicans and Geotrichum candidum Proteins
Abstract
:1. Introduction
2. Materials and Methods
2.1. Chemical Used
2.2. Henna Source and Its Pre-Treated with Moist Heat
2.3. Assessment of Phenolic and Flavonoid Constituents by HPLC
2.4. Anti-Yeast Activity of UPMH and PMH Henna Extracts
2.5. Evaluation of Minimum Inhibitory Concentration of UPMH and PMH Henna Extracts
2.6. Estimation of Minimum Fetal Concentration (MFC) of UPMH and PMH Henna Extracts
2.7. Antioxidant Activity of UPMH and PMH Henna Extracts
2.8. Healing Properties of UPMH and PMH Henna Extracts
2.9. Molecular Docking Investigation
2.10. Statistical Analysis
3. Results and Discussion
3.1. Flavonoid and Phenolic Contents of Unpre-Treated and Pre-Treated Henna by Moist Heat
3.2. Anti-Yeast Activity of Unpre-Treated and Pre-Treated Henna by Moist Heat
3.3. Healing Properties of Unpre-Treated and Pre-Treated Henna by Moist Heat
3.4. Antioxidant Properties of Unpre-Treated and Pre-Treated Henna by Moist Heat
3.5. Molecular Docking of Chlorogenic Acid and Ellagic Acid with 4ZZT Protein of G. candidum and 4YDE Protein of C. albicans
4. Conclusions
Author Contributions
Funding
Institutional Review Board Statement
Informed Consent Statement
Data Availability Statement
Acknowledgments
Conflicts of Interest
References
- Jothiprakasam, V.I.; Ramesh, S.A.; Rajasekharan, S.K. Preliminary phytochemical screening and antibacterial activity of Lawsonia inermis Linn (Henna) leaf extracts against reference bacterial strains and clinically important AMPC beta-lactamases producing Proteus mirabilis. Int. J. Pharm. Pharm. Sci. 2013, 5, 219–222. [Google Scholar]
- Rahmoun, N.; Boucherit-Otmani, Z.; Boucherit, K.; Benabdallah, M.; Choukchou-Braham, N. Antifungal activity of the Algerian Lawsonia inermis (henna). Pharm. Biol. 2013, 51, 131–135. [Google Scholar] [CrossRef]
- Yiğit, D. Antifungal activity of Lawsonia inermis L. (Henna) against clinical Candida isolates. Erzincan Univ. J. Sci. Technol. 2017, 10, 196–202. [Google Scholar]
- Supian, F.N.A.; Osman, N.I. Phytochemical and Pharmacological Activities of Natural Dye Plant, Lawsonia inermis L. (Henna). J. Young Pharm. 2023, 15, 201–211. [Google Scholar] [CrossRef]
- Coronado-Castellote, L.; Jimenez-Soriano, Y. Clinical and microbiological diagnosis of oral candidiasis. J. Clin. Exp. Dent. 2013, 5, e279–e286. [Google Scholar] [CrossRef] [PubMed]
- Hemaid, A.S.S.; Abdelghany, M.M.E.; Abdelghany, T.M. Isolation and identification of Candida spp. from immunocompromised patients. Bull. Natl. Res. Cent. 2021, 45, 163. [Google Scholar] [CrossRef]
- Badiee, P.; Alborzi, A.; Shakiba, E.; Farshad, S.; Japoni, A. Susceptibility of Candida species isolated from immunocompromised patients to antifungal agents. East. Mediterr. Health J. 2011, 17, 425–430. [Google Scholar] [CrossRef]
- Samadi, F.M.; Suhail, S.; Sonam, M.; Sharma, N.; Singh, S.; Gupta, S.; Dobhal, A.; Pradhan, H. Antifungal efficacy of herbs. J. Oral. Biol. Craniofacial Res. 2019, 9, 28–32. [Google Scholar] [CrossRef]
- Elansary, H.O.; Szopa, A.; Kubica, P.; Ekiert, H.; Al-Mana, F.A.; Al-Yafrsi, M.A. Antioxidant and biological activities of Acacia saligna and Lawsonia inermis natural populations. Plants 2020, 9, 908. [Google Scholar] [CrossRef]
- Abirami, S.; Raj, B.E.; Soundarya, T.; Kannan, M.; Sugapriya, D.; Al-Dayan, N.; Mohammed, A.A. Exploring antifungal activities of acetone extract of selected Indian medicinal plants against human dermal fungal pathogens. Saudi J. Biol. Sci. 2021, 28, 2180–2187. [Google Scholar] [CrossRef]
- Chowdhury, M.M.H.; Kubra, K.; Ahmed, S.R. Antimicrobial, Phytochemical and toxicological evaluation of Lawsonia inermis extracts against clinical isolates of pathogenic bacteria. Res. J. Med. Plant 2014, 8, 187–195. [Google Scholar] [CrossRef]
- Khodja, Y.K.; Dahmoune, F.; Bey, M.B.; Madani, K.; Khettal, B. Conventional method and microwave drying kinetics of Laurus nobilis leaves: Effects on phenolic compounds and antioxidant activity. Braz. J. Food Technol. 2020, 23, e2019214. [Google Scholar] [CrossRef]
- Al-Rajhi, A.M.H.; Qanash, H.; Almashjary, M.N.; Hazzazi, M.S.; Felemban, H.R.; Abdelghany, T.M. Anti-Helicobacter pylori, Antioxidant, Antidiabetic, and Anti-Alzheimer’s Activities of Laurel Leaf Extract Treated by Moist Heat and Molecular Docking of Its Flavonoid Constituent, Naringenin, against Acetylcholinesterase and Butyrylcholinesterase. Life 2023, 13, 1512. [Google Scholar] [CrossRef] [PubMed]
- Khoddami, A.; Wilkes, M.A.; Roberts, T.H. Techniques for Analysis of Plant Phenolic Compounds. Molecules 2013, 18, 2328–2375. [Google Scholar] [CrossRef] [PubMed]
- Al-Rajhi, A.M.H.; Qanash, H.; Bazaid, A.S.; Binsaleh, N.K.; Abdelghany, T.M. Pharmacological Evaluation of Acacia nilotica Flower Extract against Helicobacter pylori and Human Hepatocellular Carcinoma In Vitro and In Silico. J. Funct. Biomater. 2023, 14, 237. [Google Scholar] [CrossRef] [PubMed]
- Martinotti, S.; Ranzato, E. Scratch Wound Healing Assay. Methods Mol. Biol. 2020, 2109, 225–229. [Google Scholar] [CrossRef] [PubMed]
- Juániz, I.; Ludwig, I.A.; Huarte, E.; Pereira-Caro, G.; Moreno-Rojas, J.M.; Cid, C.; De Peña, M.-P. Influence of heat treatment on antioxidant capacity and (poly)phenolic compounds of selected vegetables. Food Chem. 2016, 197, 466–473. [Google Scholar] [CrossRef]
- Routray, W.; Orsat, V. Microwave-Assisted Extraction of Flavonoids: A Review. Food Bioprocess. Technol. 2012, 5, 409–424. [Google Scholar] [CrossRef]
- Dezashibi, Z.; Samarin, A.M.; Hematyar, N.; Khodaparast, M.H. Phenolics in Henna: Extraction and stability. Eur. J. Exp. Biol. 2013, 3, 38–41. [Google Scholar]
- Dobroslavić, E.; Repajić, M.; Dragović-Uzelac, V.; Garofulić, I.E. Isolation of Laurus nobilis Leaf Polyphenols: A Review on Current Techniques and Future Perspectives. Foods 2022, 11, 235. [Google Scholar] [CrossRef]
- Lee, S.; Choi, Y.; Jeong, H.S.; Lee, J.; Sung, J. Effect of different cooking methods on the content of vitamins and true retention in selected vegetables. Food Sci. Biotechnol. 2017, 27, 333–342. [Google Scholar] [CrossRef] [PubMed]
- Suleiman, E.A.; Mohamed, E.A. In vitro activity of Lawsonia inermis (Henna) on some pathogenic fungi. J. Mycol. 2014, 2014, 375932. [Google Scholar]
- Soliman, S.S.M.; Semreen, M.H.; El-Keblawy, A.A.; Abdullah, A.; Uppuluri, P.; Ibrahim, A.S. Assessment of herbal drugs for promising anti-Candida activity. BMC Complement. Altern. Med. 2017, 17, 257. [Google Scholar] [CrossRef] [PubMed]
- Kouadri, F. In vitro antibacterial and antifungal activities of the Saudi Lawsonia inermis extracts against some nosocomial infection pathogens. J. Pure Appl. Microbiol. 2018, 12, 281–286. [Google Scholar] [CrossRef]
- Yaralizadeh, M.; Abedi, P.; Namjoyan, F.; Fatahinia, M.; Chegini, S.N. A comparison of the effects of Lawsonia inermis (Iranian henna) and clotrimazole on Candida albicans in rats. J. Med. Mycol. 2018, 28, 419–423. [Google Scholar] [CrossRef]
- Daemi, A.; Farahpour, M.R.; Oryan, A.; Karimzadeh, S.; Tajer, E. Topical administration of hydroethanolic extract of Lawsonia inermis (henna) accelerates excisional wound healing process by reducing tissue inflammation and amplifying glucose uptake. Kaohsiung J. Med. Sci. 2019, 35, 24–32. [Google Scholar] [CrossRef] [PubMed]
- Miraj, S.; Zibanejad, S.; Kopaei, M.R. Healing effect of Quercus persica and Lawsonia inermis ointment on episiotomy wounds in primiparous women. J. Res. Med. Sci. 2020, 25, 11. [Google Scholar] [CrossRef] [PubMed]
- El Massoudi, S.; Zinedine, A.; Rocha, J.M.; Benidir, M.; Najjari, I.; El Ghadraoui, L.; Benjelloun, M.; Errachidi, F. Phenolic Composition and Wound Healing Potential Assessment of Moroccan Henna (Lawsonia inermis) Aqueous Extracts. Cosmetics 2023, 10, 92. [Google Scholar] [CrossRef]
- Réblová, Z. Effect of temperature on the antioxidant activity of phenolic acids. Czech J. Food Sci. 2012, 30, 171–175. [Google Scholar] [CrossRef]
- Kumar, M.; Kaur, P.; Chandel, M.; Singh, A.P.; Jain, A.; Kaur, S. Antioxidant and hepatoprotective potential of Lawsonia inermis L. leaves against 2-acetylaminofluorene induced hepatic damage in male Wistar rats. BMC Complement. Altern. Med. 2017, 17, 56. [Google Scholar] [CrossRef]
- Çubukçu, H.C.; Kılıçaslan, N.S.D.; Durak, I. Different effects of heating and freezing treatments on the antioxidant properties of broccoli, cauliflower, garlic and onion. An experimental in vitro study. Sao Paulo Med. J. 2019, 137, 407–413. [Google Scholar] [CrossRef] [PubMed]
- Qanash, H.; Alotaibi, K.; Aldarhami, A.; Bazaid, A.S.; Ganash, M.; Saeedi, N.H.; Ghany, T.A. Effectiveness of oil-based nanoemulsions with molecular docking of its antimicrobial potential. BioResources 2023, 18, 1554–1576. [Google Scholar] [CrossRef]
- Dehghan, M.; Fathinejad, F.; Farzaei, M.H.; Barzegari, E. In silico unraveling of molecular anti-neurodegenerative profile of Citrus medica flavonoids against novel pharmaceutical targets. Chem. Pap. 2023, 77, 595–610. [Google Scholar] [CrossRef]
- Al-Rajhi, A.M.H.; Yahya, R.; Abdelghany, T.M.; Fareid, M.A.; Mohamed, A.M.; Amin, B.H.; Masrahi, A.S. Anticancer, Anticoagulant, Antioxidant and Antimicrobial Activities of Thevetia peruviana Latex with Molecular Docking of Antimicrobial and Anticancer Activities. Molecules 2022, 27, 3165. [Google Scholar] [CrossRef]
- Al-Rajhi, A.M.H.; Ghany, T.M.A. Nanoemulsions of some edible oils and their antimicrobial, antioxidant, and anti-hemolytic activities. BioResources 2023, 18, 1465–1481. [Google Scholar] [CrossRef]
- Qanash, H.; Bazaid, A.S.; Aldarhami, A.; Alharbi, B.; Almashjary, M.N.; Hazzazi, M.S.; Felemban, H.R.; Abdelghany, T.M. Phytochemical Characterization and Efficacy of Artemisia judaica Extract Loaded Chitosan Nanoparticles as Inhibitors of Cancer Proliferation and Microbial Growth. Polymers 2023, 15, 391. [Google Scholar] [CrossRef] [PubMed]
- Kavepour, N.; Bayati, M.; Rahimi, M.; Aliahmadi, A.; Ebrahimi, S.N. Optimization of aqueous extraction of henna leaves (Lawsonia inermis L.) and evaluation of biological activity by HPLC-based profiling and molecular docking techniques. Chem. Eng. Res. Des. 2023, 195, 332–343. [Google Scholar] [CrossRef]
- McGeady, P.; Logan, D.A.; Wansley, D.L. A protein-farnesyl transferase inhibitor interferes with the serum-induced conversion of Candida albicans from a cellular yeast form to a filamentous form. FEMS Microbiol. Lett. 2002, 213, 41–44. [Google Scholar] [CrossRef]

| Compound | UPMH Henna Extract | PMH Henna Extract | ||||||
|---|---|---|---|---|---|---|---|---|
| Retention Time | Area | Area (%) | Conc. (µg/mL) | Retention Time | Area | Area (%) | Conc. (µg/mL) | |
| Gallic acid | 3.593 | 2113.04 | 8.9652 | 9349.90 | 3.591 | 7310.95 | 30.9495 | 32,349.91 |
| Chlorogenic acid | 4.309 | 8503.60 | 36.0792 | 57,017.33 | 4.317 | 6604.92 | 27.9606 | 44,286.51 |
| Catechin | 4.611 | 91.37 | 0.3877 | 1049.75 | 4.623 | 36.99 | 0.1566 | 424.95 |
| Methyl gallate | 5.617 | 67.04 | 0.2844 | 173.53 | 5.632 | 28.98 | 0.1227 | 75.00 |
| Caffeic acid | 5.834 | 358.26 | 1.5200 | 1469.54 | 6.017 | 103.97 | 0.4401 | 426.45 |
| Syringic acid | 6.521 | 35.46 | 0.1504 | 138.64 | 6.538 | 33.00 | 0.1397 | 129.02 |
| Pyrocatechol | 6.675 | 100.78 | 0.4276 | 819.19 | 6.652 | 0.00 | 0.00 | 0.00 |
| Rutin | 6.939 | 1493.20 | 6.3354 | 15,059.88 | 6.983 | 377.75 | 1.5991 | 3809.85 |
| Ellagic acid | 7.335 | 5712.41 | 24.2367 | 25,821.09 | 7.339 | 3963.18 | 16.7774 | 17,914.26 |
| Coumaric acid | 8.733 | 145.80 | 145.7976 | 270.56 | 8.731 | 216.64 | 0.9171 | 402.02 |
| Vanillin | 9.027 | 4.98 | 4.97855 | 9.41 | 9.036 | 4.57 | 0.0193 | 8.63 |
| Ferulic acid | 9.895 | 26.99 | 0.1145 | 82.29 | 9.886 | 41.57 | 0.1760 | 126.72 |
| Naringenin | 10.303 | 27.96 | 0.1186 | 133.45 | 10.305 | 449.88 | 1.9045 | 2146.89 |
| Rosmarinic acid | 11.641 | 1155.13 | 4.9010 | 6345.08 | 11.637 | 1048.63 | 4.4392 | 5760.05 |
| Daidzein | 15.892 | 86.45 | 86.4480 | 251.57 | 15.893 | 113.65 | 0.4811 | 330.74 |
| Quercetin | 17.289 | 15.82 | 0.0671 | 96.76 | 17.557 | 207.59 | 0.8788 | 1269.47 |
| Cinnamic acid | 19.431 | 38.59 | 0.1637 | 35.39 | 19.270 | 41.77 | 0.1768 | 35.30 |
| Kaempferol | 20.370 | 373.40 | 1.5843 | 1248.42 | 20.820 | 14.66 | 0.0621 | 49.01 |
| Hesperetin | 21.116 | 44.49 | 0.1888 | 118.00 | 21.153 | 122.14 | 0.5171 | 323.97 |
| Mean Inhibition Zone (mm) | MIC (µg/mL) | MFC (µg/mL) | MFC/MIC Index | |||||||
|---|---|---|---|---|---|---|---|---|---|---|
| UPMH | PMH | +ve C | −ve C | UPMH | PMH | UPMH | PMH | UPMH | PMH | |
| C. albicans | 30.17 ± 0.29 a | 29.00 ± 0.50 b | 26.0 ± 1.32 c | 0.0 | 15.63 ± 0.09 a | 15.64 ± 0.07 b | 31.23 ± 0.03 a | 31.25 ± 0.25 a | 1.99 | 1.99 |
| C. tropicalis | 27.0 ± 0.50 a | 25.33 ± 0.58 b | 25.17 ± 0.76 b | 0.0 | 62.50 ± 1.00 a | 125.33 ± 1.53 b | 125 ± 3.0 a | 249.67 ± 1.53 b | 2.0 | 1.99 |
| G. candidum | 29.0 ± 1.50 a | 24.17 ± 0.29 b | 27.0 ± 1.00 c | 0.0 | 7.83 ± 0.35 a | 15.62 ± 0.02 b | 7.8 ± 0.20 a | 15.62 ± 0.04 b | 0.99 | 1.0 |
| Treatment | At 0 h | At 24 h | At 48 h | RM um | Wound Closure % um2 | Area Difference % | |||
|---|---|---|---|---|---|---|---|---|---|
| Area | Width | Area | Width | Area | Width | ||||
| Control (without treatment) | 885 | 884.081 | 737 | 736.024 | 381 | 380.021 | 11.554 a | 58.903 a | 554.667 a |
| 937 | 936.009 | 737 | 736.000 | 377 | 376.021 | ||||
| 959 | 958.052 | 741 | 740.219 | 361 | 360.355 | ||||
| 945 | 944.008 | 837 | 836.038 | 337 | 336.095 | ||||
| 959 | 958.000 | 849 | 848.021 | 413 | 412.000 | ||||
| 965 | 964.000 | 843 | 842.086 | 453 | 452.004 | ||||
| Mean | |||||||||
| 941.667 | 940.692 | 790.667 | 789.731 | 387 | 386.083 | ||||
| Extract of UPMH henna | 931 | 930.002 | 813 | 812.089 | 249 | 248.008 | 14.806 b | 74.938 b | 710.667 b |
| 953 | 952.034 | 819 | 818.002 | 281 | 280.007 | ||||
| 945 | 944.172 | 823 | 822.01 | 249 | 248.129 | ||||
| 943 | 942.034 | 837 | 836.117 | 183 | 182.176 | ||||
| 971 | 970.132 | 749 | 748 | 229 | 228.000 | ||||
| 947 | 946.008 | 763 | 762.042 | 235 | 234.034 | ||||
| Mean | |||||||||
| 948.333 | 947.397 | 800.667 | 799.71 | 237.667 | 236.726 | ||||
| Extract of PMH henna | 913 | 912.020 | 845 | 844.009 | 305 | 304.105 | 11.360 c | 59.083 c | 545.333 c |
| 923 | 922.020 | 887 | 886.009 | 255 | 254.031 | ||||
| 919 | 918.035 | 839 | 838.01 | 337 | 336.381 | ||||
| 947 | 946.002 | 885 | 884.274 | 447 | 446.000 | ||||
| 917 | 916.020 | 885 | 884.081 | 479 | 478.004 | ||||
| 919 | 918.002 | 847 | 846.002 | 443 | 442.018 | ||||
| Mean | |||||||||
| 923 | 922.017 | 864.667 | 863.731 | 377.667 | 376.757 | ||||
| Concentration (µg/mL) | DPPH Scavenging % | ||
|---|---|---|---|
| UPMH | PMH | Ascorbic Acid | |
| 1000 | 98.5 a | 97.7 a | 99.3 ab |
| 500 | 95.0 a | 94.5 a | 96.3 b |
| 250 | 90.8 a | 90.1 a | 94.8 b |
| 125 | 83.2 a | 82.6 a | 91.9 b |
| 62.50 | 75.6 a | 74.4 a | 84.2 b |
| 31.25 | 69.1 a | 66.5 b | 76.1 c |
| 15.63 | 61.7 a | 59.3 b | 67.6 c |
| 7.81 | 53.3 a | 50.9 b | 60.4 c |
| 3.90 | 45.5 a | 41.5 b | 52.1 c |
| 1.95 | 37.8 a | 33.2 b | 43.7 c |
| 0.0 | 0.0 | 0.0 | 0.0 |
| IC50 | 5.46 µg/mL | 7.46 µg/mL | 2.52 µg/mL |
| Mol | S | Rmsd_Refine | E_Conf | E_Place | E_Score1 | E_Refine | E_Score2 |
|---|---|---|---|---|---|---|---|
| Chlorogenic acid | −5.69876 | 1.6749115 | −2.57228 | −41.8448 | −11.4368 | −30.2837 | −5.69876 |
| Chlorogenic acid | −5.65288 | 1.729309 | −2.45688 | −57.55 | −12.6225 | −28.5364 | −5.65288 |
| Chlorogenic acid | −5.58586 | 1.9682481 | 14.59859 | −48.7804 | −12.7552 | −28.076 | −5.58586 |
| Chlorogenic acid | −5.44998 | 1.4506954 | 9.080463 | −45.4938 | −11.5779 | −26.7653 | −5.44998 |
| Chlorogenic acid | −5.41043 | 2.7580004 | 3.998731 | −46.4482 | −12.3195 | −27.2703 | −5.41043 |
| Ellagic acid | −4.5145 | 4.868453 | 14.66806 | −16.8034 | −6.74256 | −25.2636 | −4.5145 |
| Ellagic acid | −4.23481 | 3.9006364 | 16.43244 | −48.9339 | −7.72468 | −19.8999 | −4.23481 |
| Ellagic acid | −4.2133 | 4.5235729 | 14.63135 | 7.640516 | −6.31675 | −19.1073 | −4.2133 |
| Ellagic acid | −4.11208 | 3.4813149 | 14.97426 | −26.417 | −8.96398 | −18.4696 | −4.11208 |
| Ellagic acid | −4.08451 | 2.8578191 | 14.7638 | −21.7358 | −6.67745 | −16.6032 | −4.08451 |
| Mol | S | Rmsd_Refine | E_Conf | E_Place | E_Score1 | E_Refine | E_Score2 |
|---|---|---|---|---|---|---|---|
| Chlorogenic acid | −7.84379 | 1.9669101 | 0.067377 | −99.6069 | −12.9229 | −50.3995 | −7.84379 |
| Chlorogenic acid | −7.25803 | 1.8288656 | 12.89607 | −99.626 | −13.0726 | −46.7111 | −7.25803 |
| Chlorogenic acid | −7.23898 | 2.5565467 | 5.357535 | −91.2855 | −12.8967 | −46.316 | −7.23898 |
| Chlorogenic acid | −7.23589 | 2.2799456 | 14.8198 | −101.412 | −13.962 | −45.1973 | −7.23589 |
| Chlorogenic acid | −7.12938 | 1.8402419 | 12.1299 | −83.0073 | −13.2714 | −44.543 | −7.12938 |
| Ellagic acid | −6.18615 | 0.88734156 | 15.62339 | −92.791 | −13.3693 | −39.0664 | −6.18615 |
| Ellagic acid | −6.08951 | 1.0905997 | 17.58312 | −94.3595 | −13.0066 | −37.9829 | −6.08951 |
| Ellagic acid | −6.08205 | 1.4268098 | 15.37853 | −85.0092 | −12.7316 | −33.7174 | −6.08205 |
| Ellagic acid | −6.07779 | 1.5727613 | 16.8008 | −94.8967 | −12.7112 | −34.4453 | −6.07779 |
| Ellagic acid | −6.07731 | 2.3918681 | 15.11539 | −88.7238 | −13.13 | −34.386 | −6.07731 |
| Mol | Ligand | Receptor | Interaction | Distance | E (kcal/mol) | ||||
|---|---|---|---|---|---|---|---|---|---|
| Chlorogenic acid | C | 26 | OD1 | ASP | 527 | (B) | H-donor | 3.48 | −0.5 |
| O | 40 | OD2 | ASP | 569 | (B) | H-donor | 2.94 | −2.0 | |
| O | 23 | NZ | LYS | 512 | (B) | H-acceptor | 3.18 | −0.8 | |
| Ellagic acid | O | 20 | OD1 | ASP | 527 | (B) | H-donor | 2.84 | −5.0 |
| Mol | Ligand | Receptor | Interaction | Distance | E (kcal/mol) | ||||
|---|---|---|---|---|---|---|---|---|---|
| Chlorogenic acid | O | 19 | OE2 | GLU | 217 | (A) | H-donor | 2.80 | −3.8 |
| O | 17 | NE2 | GLN | 175 | (A) | H-acceptor | 2.97 | −1.1 | |
| O | 19 | NE2 | HIS | 228 | (A) | H-acceptor | 3.24 | −1.7 | |
| C | 1 | 6-ring | TRP | 380 | (A) | H-pi | 3.91 | −0.6 | |
| 6-ring | 5-ring | TRP | 371 | (A) | pi-pi | 3.61 | −0.0 | ||
| Ellagic acid | O | 20 | OE2 | GLU | 217 | (A) | H-donor | 2.67 | −6.2 |
| O | 22 | OG1 | THR | 226 | (A) | H-donor | 3.20 | −1.2 | |
| O | 24 | NH1 | ARG | 399 | (A) | H-acceptor | 3.08 | −2.4 | |
| 6-ring | NH2 | ARG | 251 | (A) | pi-cation | 4.09 | −3.2 | ||
Disclaimer/Publisher’s Note: The statements, opinions and data contained in all publications are solely those of the individual author(s) and contributor(s) and not of MDPI and/or the editor(s). MDPI and/or the editor(s) disclaim responsibility for any injury to people or property resulting from any ideas, methods, instructions or products referred to in the content. |
© 2023 by the authors. Licensee MDPI, Basel, Switzerland. This article is an open access article distributed under the terms and conditions of the Creative Commons Attribution (CC BY) license (https://creativecommons.org/licenses/by/4.0/).
Share and Cite
Alsalamah, S.A.; Alghonaim, M.I.; Jusstaniah, M.; Abdelghany, T.M. Anti-Yeasts, Antioxidant and Healing Properties of Henna Pre-Treated by Moist Heat and Molecular Docking of Its Major Constituents, Chlorogenic and Ellagic Acids, with Candida albicans and Geotrichum candidum Proteins. Life 2023, 13, 1839. https://doi.org/10.3390/life13091839
Alsalamah SA, Alghonaim MI, Jusstaniah M, Abdelghany TM. Anti-Yeasts, Antioxidant and Healing Properties of Henna Pre-Treated by Moist Heat and Molecular Docking of Its Major Constituents, Chlorogenic and Ellagic Acids, with Candida albicans and Geotrichum candidum Proteins. Life. 2023; 13(9):1839. https://doi.org/10.3390/life13091839
Chicago/Turabian StyleAlsalamah, Sulaiman A., Mohammed Ibrahim Alghonaim, Mohammed Jusstaniah, and Tarek M. Abdelghany. 2023. "Anti-Yeasts, Antioxidant and Healing Properties of Henna Pre-Treated by Moist Heat and Molecular Docking of Its Major Constituents, Chlorogenic and Ellagic Acids, with Candida albicans and Geotrichum candidum Proteins" Life 13, no. 9: 1839. https://doi.org/10.3390/life13091839
APA StyleAlsalamah, S. A., Alghonaim, M. I., Jusstaniah, M., & Abdelghany, T. M. (2023). Anti-Yeasts, Antioxidant and Healing Properties of Henna Pre-Treated by Moist Heat and Molecular Docking of Its Major Constituents, Chlorogenic and Ellagic Acids, with Candida albicans and Geotrichum candidum Proteins. Life, 13(9), 1839. https://doi.org/10.3390/life13091839

